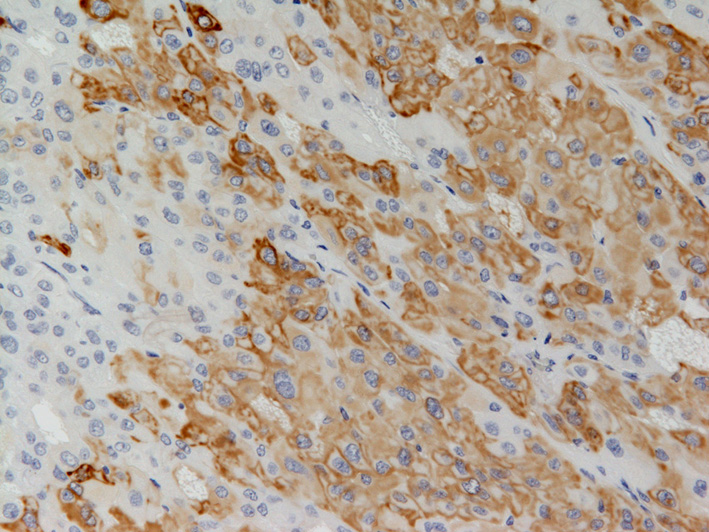

| 第 64 回 日本病理学会東北支部学術集会(JSP
−TN) 抄録データベース |
| 演題番号 |
03 |
区分 |
B. 典型的・教育的・その他の症例 |
| 出題者および所属 |
|
池田 仁1),大芦 孝平2),木村 中2)
函館中央病院 病理検査科1),形成外科2) |
|
| 症例の概要・問題点 |
| 症例 |
63歳 女性 |
| 既往歴 |
特記すべきものなし |
| 現病歴 |
約3年前より左耳下部に腫瘤を触知,徐々に大きくなってきたので当院を受診.左耳下腺浅葉内に約1cm大の充実性腫瘍を認め,周囲耳下腺組織を含め,摘出した. |
| 肉眼所見 |
耳下腺内の被膜を有した約1.2x1.0x1.0cmの境界明瞭な黄灰白色調の充実性腫瘍 |
| 配布標本 |
腫瘍を含む唾液腺組織. |
|
|
| 問題点 |
病理診断 |
| 最終病理診断 |
Myoepithelioma |
|
|
| 診断 |
Myoepithelioma, epithelioid type with oncocytic feature |
| コメント |
Myoepitheliomaは多彩の形態をとるため,種々の唾液腺腫瘍との鑑別が必要である.今回のようにoncocyticな細胞が主体となる場合も報告(Virchows Arch, 434:537-546, 1999)されており,そのような場合はvimentinやS100など免疫染色を併用して診断することが重要である.なお,良悪の鑑別には,被膜形成や浸潤の有無が重要である. |
|
|
|
|
|
|
|
|
|
|
|
|
|
|
|
|
|
|
|
|
画像1
|
画像2
|
 |
 |
| 腫瘍のルーペ像.唾液腺内の線維性被膜を有した境界明瞭な充実性腫瘍. |
腫瘍は好酸性細顆粒状の豊富な胞体を有した比較的均一な細胞の胞巣状充実性増殖からなっている(HE染色,対物x20). |
|
|
画像3
|
画像4
|
|
 |
| CK7の免疫染色(対物x20).腫瘍細胞の多くは陽性であるが,所々で陰性細胞集塊を混在する. |
S100の免疫染色(対物x20).腫瘍細胞のほとんどに陽性像を示す. |
|
|
|
|
|
|
|
|
|
|
|